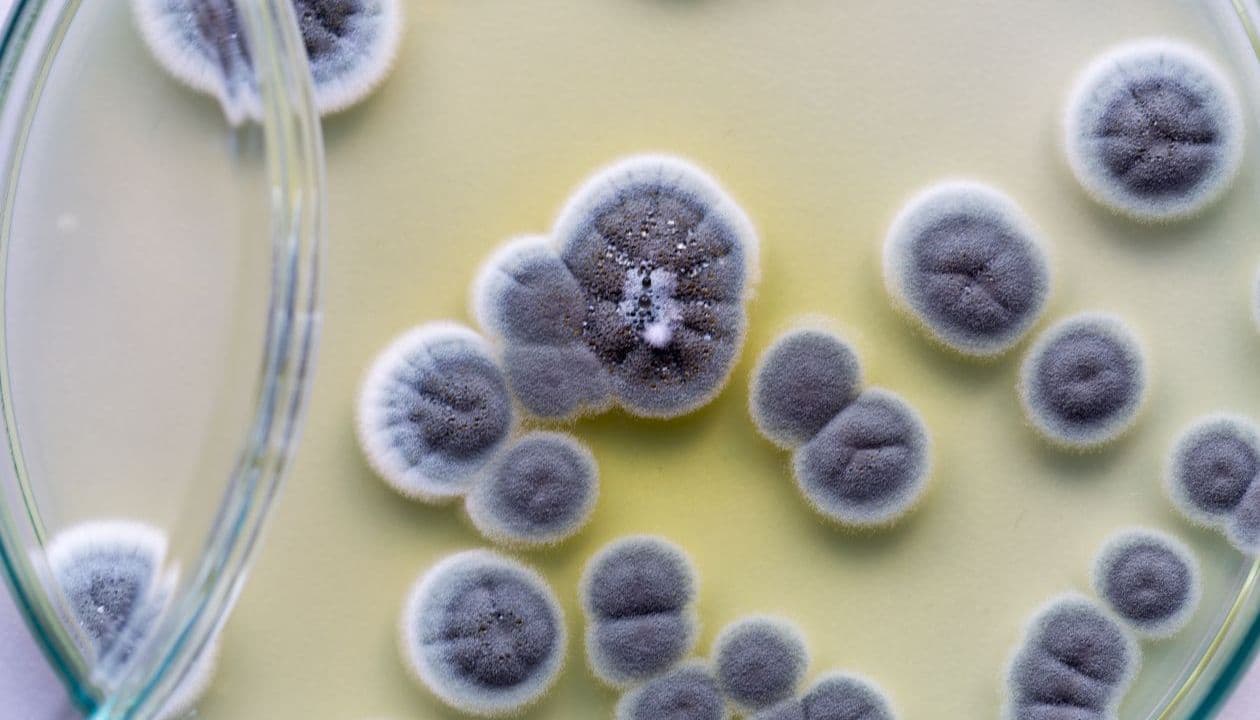
What causes sinusitis?

Sinusitis is inflammation of the mucosal lining of the paranasal sinuses. It can present in acute, subacute, or chronic forms depending on symptom duration and severity. Blocked sinus drainage and microbial overgrowth contribute to facial pressure, pain, and impaired breathing.
What is sinus infection?
Sinus infection, also known as sinusitis, occurs when the mucosal lining of the paranasal sinuses becomes inflamed and swollen, disrupting normal drainage and creating an environment for microbial overgrowth. The sinuses are air-filled cavities in the facial bones that produce mucus to trap pathogens and debris, and when their narrow ostia become obstructed by viral infections, allergies, anatomical variations, or environmental irritants, mucus accumulates, leading to pressure and pain. Acute bacterial sinusitis typically follows a viral upper respiratory infection and is characterized by nasal congestion, purulent nasal discharge, facial tenderness, headache, and decreased sense of smell, with most episodes resolving within four weeks. When symptoms persist beyond twelve weeks or recur multiple times annually, the condition is classified as chronic or recurrent acute sinusitis, often involving more complex factors such as biofilm formation, fungal colonization, and chronic inflammation. Diagnosis relies primarily on clinical history and physical examination, supported by nasal endoscopy or imaging in complicated cases. Treatment strategies include saline irrigation, intranasal corticosteroids, and, when indicated, short courses of antibiotics tailored to likely pathogens. Addressing underlying issues—such as allergic inflammation, structural nasal obstruction, or immune deficiencies—is crucial to preventing recurrence and restoring sinus health and improving overall patient long-term well-being.

What causes sinusitis?
Sinusitis arises when the delicate mucosal lining of the paranasal sinuses becomes inflamed and swollen, disrupting normal mucus drainage and creating a fertile environment for microbial overgrowth. The most common precipitant is a viral upper respiratory infection, which triggers mucosal edema and ciliary dysfunction, allowing secretions to stagnate. Secondary bacterial infection can follow if opportunistic pathogens such as Streptococcus pneumoniae, Haemophilus influenzae, or Moraxella catarrhalis proliferate within the obstructed sinus cavities. Allergic inflammation driven by inhalant allergens like pollen, dust mites, or animal dander also contributes through repeated cycles of mucosal swelling and blockage, while environmental irritants—including tobacco smoke, air pollution, and chemical fumes—can provoke chronic mucociliary impairment. Anatomical factors such as a deviated nasal septum, concha bullosa, or nasal polyps further narrow sinus ostia, hindering ventilation and predisposing individuals to recurrent episodes. Less frequently, fungal colonization or invasive fungal sinusitis occurs in immunocompromised patients. Underlying risk factors such as immunodeficiency, ciliary motility disorders, and gastroesophageal reflux may also play roles by impairing host defenses or altering mucosal integrity.
Types of Sinusitis
Sinusitis is classified into distinct types according to symptom duration and recurrence patterns, enabling targeted diagnostic and therapeutic approaches.
Acute sinusitis typically lasts up to four weeks, often follows a viral upper respiratory infection, and presents with sudden nasal congestion, purulent nasal discharge, facial pain or pressure, and sometimes low-grade fever.
When symptoms persist for four to twelve weeks without resolution, the condition is termed subacute sinusitis, reflecting slower recovery and potential need for extended therapy.
Chronic sinusitis is defined by ongoing symptoms lasting twelve weeks or more despite appropriate medical management; it frequently involves underlying factors such as nasal polyps, anatomic variations, or bacterial biofilms, and manifests with persistent nasal obstruction, postnasal drip, reduced olfaction, and facial discomfort.
Recurrent acute sinusitis describes multiple acute episodes—commonly four or more—within a twelve-month period, each separated by symptom-free intervals, highlighting predisposition to repeated infections.
A specialized form, allergic fungal sinusitis, arises from type I hypersensitivity to fungal antigens and is characterized by eosinophilic mucin and sinus opacification on imaging studies.
Recognizing these subtypes guides clinicians in selecting optimal evaluations—like nasal endoscopy and CT scanning—and tailoring treatments ranging from saline irrigation and intranasal steroids to antibiotics and, when necessary, endoscopic sinus surgery.

What are the Symptoms of sinusitis?
Sinusitis is characterized by a constellation of symptoms reflecting inflammation and obstruction of the paranasal sinuses. Symptoms often begin with persistent nasal congestion and obstruction, leading to difficulty breathing through the nose and a sensation of fullness behind the eyes. Facial pain or pressure, which may intensify when bending forward or upon waking in the morning, commonly affects the cheeks, forehead, or around the eyes and can range from a dull ache to severe discomfort. Purulent or discolored nasal discharge—yellow or green in color—often accompanies the congestion and may drip down the back of the throat as postnasal drip, provoking throat irritation and a persistent cough. Reduced or lost sense of smell (hyposmia or anosmia) and taste frequently occur, diminishing appetite and quality of life. Patients may experience headaches that mirror tension-type or migraine patterns, a low-grade fever, ear fullness, and even dental pain in the upper jaw. Fatigue and malaise often accompany severe cases, compounded by disturbed sleep due to nocturnal coughing and congestion. In chronic sinusitis, these symptoms persist for more than twelve weeks and may be less intense but more refractory to treatment. Recognizing both signs and their duration is crucial for accurate diagnosis and effective management.

How can sinusitis be treated?
Treating sinusitis effectively requires a combination of medical therapies, supportive measures, and, in selected cases, surgical intervention. For most patients with acute viral or mild bacterial sinusitis, nasal saline irrigation and intranasal corticosteroids reduce mucosal swelling, improve sinus drainage, and alleviate congestion within days. Short-term oral decongestants or topical nasal decongestant sprays used judiciously for no more than three days can ease pressure and improve breathing, while analgesics such as acetaminophen or ibuprofen manage facial pain and headache. When bacterial infection is suspected—characterized by persistent symptoms beyond ten days, purulent nasal discharge, or high fever—a targeted, short-course antibiotic is indicated, ideally guided by regional resistance patterns. In chronic or refractory cases, prolonged topical corticosteroid therapy, mucolytic agents, and adjunctive modifications—including allergen avoidance, treatment of underlying allergic rhinitis, and management of gastroesophageal reflux—can restore mucociliary function. Functional endoscopic sinus surgery is reserved for patients who fail maximal medical therapy or who have anatomic obstructions, allowing restoration of ventilation and drainage. Emerging treatments such as topical antibiotic or antifungal irrigations, balloon sinuplasty, and monoclonal antibodies targeting key inflammatory pathways offer promising alternatives, and patient education support enhances adherence.

Conclusion
Sinusitis represents a complex interplay of inflammation, obstruction, and infection within the paranasal sinuses that, if left unchecked, can significantly impair breathing, sleep quality, and overall well-being. Whether manifesting acutely after a common cold or persisting as chronic, recurrent inflammation driven by anatomical variations, allergies, or biofilm formation, successful resolution hinges on timely diagnosis and a tailored treatment plan. Medical therapies—from saline irrigation and intranasal steroids to appropriate antibiotic or antifungal courses—remain first-line, while functional endoscopic sinus surgery and emerging interventions like balloon dilatation or biologic agents offer options for refractory cases. Equally vital are patient-centered strategies: identifying personal triggers, adhering to maintenance regimens, and integrating lifestyle modifications such as allergen control and smoking cessation.
Read More
